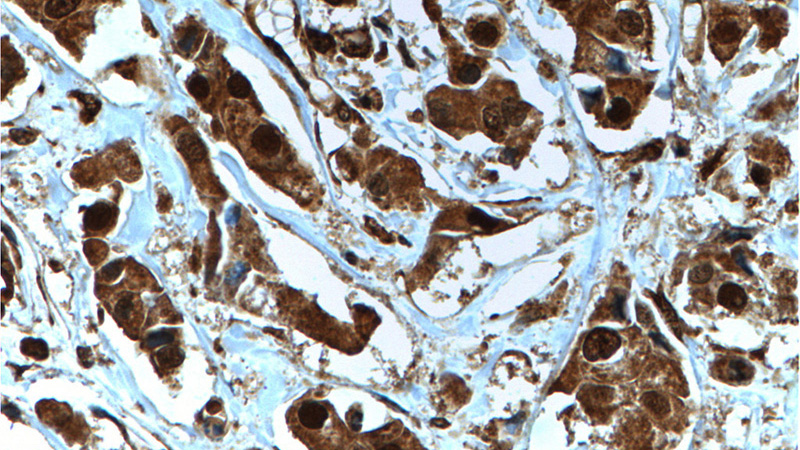
Immunohistochemistry of paraffin-embedded human breast cancer tissue slide using Catalog No:107334(NOB1 Antibody) at dilution of 1:200 (under 40x lens). heat mediated antigen retrieved with Tris-EDTA buffer(pH9).

-
Product Name
NOB1 antibody
- Documents
-
Description
NOB1 Mouse Monoclonal antibody. Positive WB detected in Jurkat cells, human placenta tissue. Positive IHC detected in human breast cancer tissue. Observed molecular weight by Western-blot: 47 kDa
-
Tested applications
ELISA, WB, IHC
-
Species reactivity
Human; other species not tested.
-
Alternative names
ART 4 antibody; ART4 antibody; MST158 antibody; MSTP158 antibody; NOB1 antibody; NOB1P antibody; Protein ART 4 antibody; PSMD8BP1 antibody; RNA binding protein NOB1 antibody
-
Isotype
Mouse IgG1
-
Preparation
This antibody was obtained by immunization of NOB1 recombinant protein (Accession Number: BC000050). Purification method: Protein G purified.
-
Clonality
Monoclonal
-
Formulation
PBS with 0.02% sodium azide and 50% glycerol pH 7.3.
-
Storage instructions
Store at -20℃. DO NOT ALIQUOT
-
Applications
Recommended Dilution:
WB: 1:1000-1:10000
IHC: 1:20-1:200
-
Validations

Jurkat cells were subjected to SDS PAGE followed by western blot with Catalog No:107334(NOB1 Antibody) at dilution of 1:3000

Immunohistochemistry of paraffin-embedded human breast cancer tissue slide using Catalog No:107334(NOB1 Antibody) at dilution of 1:200 (under 10x lens). heat mediated antigen retrieved with Tris-EDTA buffer(pH9).
Immunohistochemistry of paraffin-embedded human breast cancer tissue slide using Catalog No:107334(NOB1 Antibody) at dilution of 1:200 (under 40x lens). heat mediated antigen retrieved with Tris-EDTA buffer(pH9).
-
Background
NOB1 was first identified in yeast as an essential gene encoding the Nin one binding protein, which is involved in pre-rRNA processing. In a late cytoplasmic processing step, Nob1 cleaves a 20S rRNA intermediate at cleavage site D to produce the mature 18S rRNA. In addition, NOB1 is a crucial molecule in the maturation of the 20S proteasome and protein degradation. It serves as a chaperone to join the 20S proteasome with the 19S regulatory particle in the nucleus and facilitates the maturation of the 20S proteasome. Recently NOB1 has been reported to be overexpressed in several types of cancer, suggesting its involvement in the tumorigenesis.
Related Products / Services
Please note: All products are "FOR RESEARCH USE ONLY AND ARE NOT INTENDED FOR DIAGNOSTIC OR THERAPEUTIC USE"
